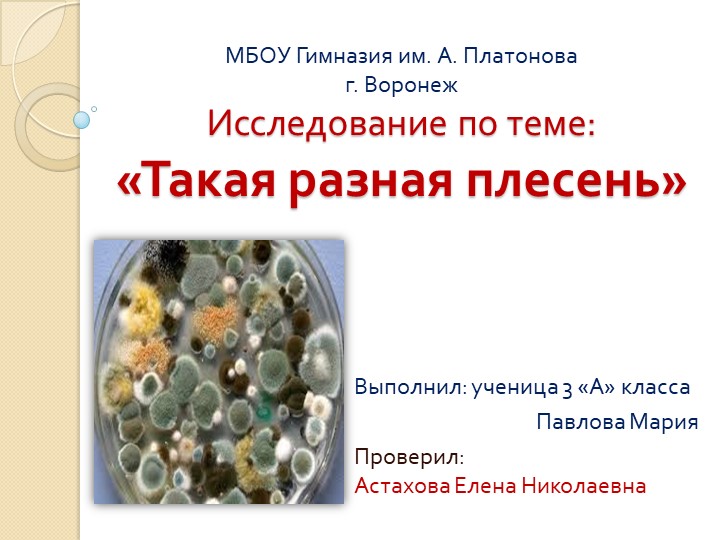
Презентация на тему "Такая разная плесень"  - Скачать презентации бесплатно | Читать или скачать учебники для школы онлайн бесплатно ☑ Школьные учебники school-textbook.com

Презентация на тему: "Презентация по географии "Интеллектуальная викторина "Такая разная география"""

- Категория: Презентации / Другие презентации
- Просмотров: 128
Презентация "Презентация по географии "Интеллектуальная викторина "Такая разная география""" онлайн бесплатно или скачать на сайте электронных школьных учебников/презентаций school-textbook.com
Интеллектуальная викторина
«Такая разная география»
Автор составитель:
Шатская Н.В., учитель географии
Томичи
Как известно жителей Москвы называют москвичи, а как называют жителей Томска?
Ты кто такой?
Куряне
Как известно, жителей Красноярска называют красноярцы, а как называют жителей Курска?
Ты кто такой?
В Набережных Челнах, Татария
Как вы знаете японцы живут в Японии, чилийцы - в Чили, а где живут Челнинцы?
Ты кто такой?
Греческий
В России - язык русский,
Во Франции - французский,
В Германии - немецкий,
А в Греции –?
Ты кто такой?
Монегаски
Как известно, жителей оружейной столицы России -Тулы называют туляками, а как называют жителей Монако?
Ты кто такой?